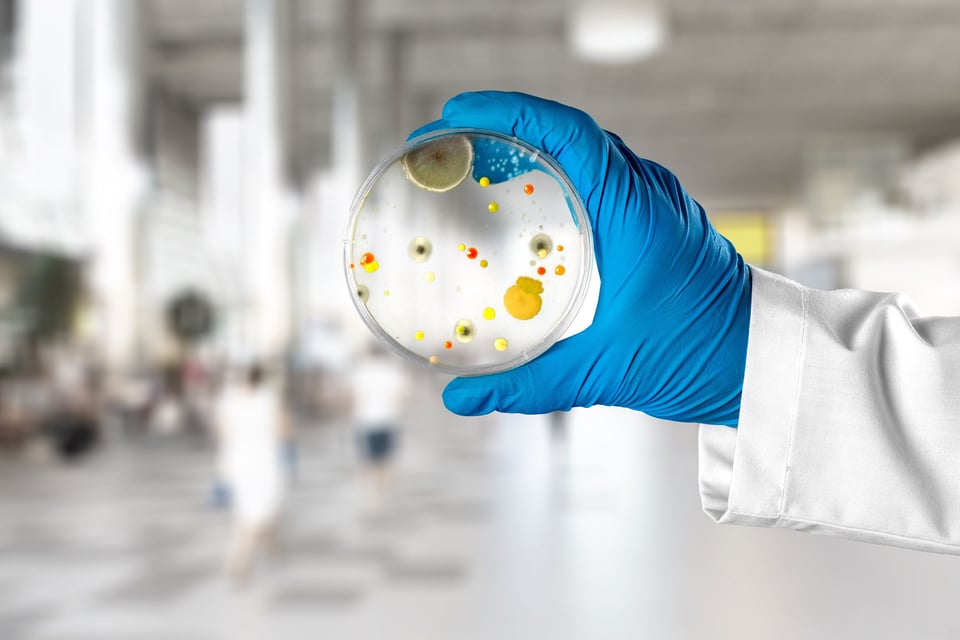

The European Food Safety Authority (EFSA) has significantly refined its methodology for assessing antimicrobial resistance (AMR) in microorganisms used in the food chain. What began as a focus on avoiding transferable resistance has evolved into a genome-based framework for distinguishing intrinsic and acquired AMR genes, a two-decade shift that now defines whether microbial strains qualify for Qualified Presumption of Safety (QPS) and can be used safely in commercial applications.
Early guidance: Focus on transferability
Europe recognized the need to control antibiotic resistance in feed additives already in the 1990s, initially leading to the prohibition of avoparcin in January 1997 (Directive 97/6/EC). At the end of the 1990s, a multidisciplinary Working Group of the Commission’s Scientific Steering Committee undertook a major review on the wider resistance issue. Prudent use of antimicrobials both in human and veterinary medicine, as well as in animal production and plant protection, was highlighted.
In 2001 (update 2003), the EC’s Scientific Committee for Animal Nutrition (SCAN) expressed an opinion on the criteria for assessing safety of microbial feed additives resistant to antibiotics. The concepts of intrinsic and acquired (transferable) resistance were introduced. Intrinsic or natural resistance is inherent to a bacterial species or genus. Some strains within a usually susceptible species may acquire resistance, however the potential for resistance spreading is high only if the resistance gene is on a mobile element (plasmid, transposon). SCAN set the stage for EFSA’s approach by concluding that strains of bacteria carrying an acquired resistance to antibiotics used in human and veterinary medicine should not be used in feed additives, unless the resistance is based on a mutation in an intrinsic gene. Viable microbes should not add to the pool of transferable antibiotic resistance genes.
Let's review how the EFSA guidance has evolved and what impact it has had on both AMR risk and microbial innovation.
EFSA FEEDAP technical guidance 2008: Reaffirming the intrinsic vs. acquired distinction
Building on SCAN opinion, the EFSA Panel on Additives and Products in Animal Feed (FEEDAP) updated the criteria for antibiotic resistance in feed additives. The key concern was if a bacterial strain carries resistance genes that could be transferred to other bacteria, particularly those in the gut microbiota of animals or humans.
Intrinsic resistance was understood as a natural, species-wide trait, typically chromosomal and non-transferable. Acquired resistance referred to resistance gained through horizontal gene transfer (e.g., plasmids, transposons), which poses a higher risk of dissemination.
EFSA’s 2008 and 2012 guidance documents required applicants to demonstrate the absence of acquired resistance genes to clinically relevant antibiotics. If a strain showed elevated resistance levels, further genetic analysis was mandated to determine whether the resistance was intrinsic or acquired. Strains with acquired resistance genes were generally deemed unsuitable for use.
Shift in 2018: Genomic characterization and AMR gene classification
The 2018 FEEDAP guidance marked a turning point. EFSA started requiring whole genome sequencing (WGS) for all bacterial strains intended for food and feed additives. This allowed for direct identification of known AMR genes and a more precise classification of their nature.
Key updates included:
-
Mandatory WGS analysis to detect potential AMR genes.
-
Classification of each gene as intrinsic or acquired based on its prevalence in the species.
-
Intrinsic genes (common to all strains of a species) were not considered a safety concern.
-
Acquired genes (atypical for the species) triggered further investigation and were treated as potential hazards.
This approach allowed EFSA to move beyond phenotypic resistance testing and rely on curated genomic databases to assess the risk posed by specific resistance genes.
2023 BIOHAZ Panel statement: Harmonizing definitions
EFSA’s BIOHAZ Panel (EFSA Panel on Biological Hazards) issued a statement in 2023 to clarify how AMR genes should be interpreted in the context of the Qualified Presumption of Safety (QPS) framework. The statement provided standardized definitions:
-
Intrinsic AMR genes: Inherent to the species, found in the vast majority of wild-type strains (based on analysis of at least 30 independent strains), and typically chromosomal. These are not considered safety concerns.
-
Acquired AMR genes: Present in only some strains, often located on plasmids or other mobile elements, and potentially transferable. These are considered hazards and disqualify a strain from QPS status unless further risk assessment is conducted.
The statement also introduced general principles and criteria to help applicants and assessors determine the nature of detected AMR genes.
EFSA’s intrinsic-vs-acquired criterion is essentially a screen for transfer potential. The “acquired” nature of an AMR gene is used as a surrogate marker for transferability, as evidence for mobility or reliable laboratory demonstration of transfer is hard to achieve.
Challenges and considerations for innovation
EFSA has thus chosen a precautionary approach. In practice, this leads companies to avoid strains where intrinsic resistance cannot be proven. Companies screen their candidate strains and, if they find potentially acquired resistance genes, either abandon those strains or “cure” them.
This is feasible in many cases. However, challenges arise when the genomes of only one or a few representatives of a species are available. In such cases, it may be difficult to prove that an AMR gene is intrinsic, even though the gene is chromosomal and shows no indication of mobility. The requirement of 30 non-clonal strains is often not achievable for novel or rare species. While EFSA accepts scientific arguments, the applicants are left with high uncertainty.
This situation is particularly discouraging for innovations involving new bacterial species. The guidance documents do not provide a clear path forward when there is no real indication of a gene being acquired.
A more granulated approach could be considered. For example, allowing a strain with a gene that cannot be categorised as acquired or intrinsic if it can be shown that the gene is chromosomal, likely non-mobile, and has not been reported to transfer. This is especially relevant if the antibiotic is no longer used commonly, or if the strain is susceptible to alternative antibiotics.
From a scientific and ecological perspective, the concept of “adding to the pool” is also highly relevant. It reflects the idea that the risk is not only about transferability, but also about novelty and capacity of multiplication of the strain.
The risk assessments could benefit from contextualizing AMR genes within the existing resistome of the target environment. For example:
-
If a strain carries a resistance gene that is already common in the gut microbiota, and the gene is not located on a mobile element, then the strain might not significantly alter the resistome.
-
If the same gene is rare or absent in the gut, its introduction, even in a non-mobile form, could increase the diversity and availability of resistance traits, especially if future mutations or recombination events can mobilize it.
Putting AMR risk in perspective
There is broad scientific consensus that the primary drivers of AMR emergence and spread lie elsewhere; not in microorganisms intentionally added to food, such as probiotics or feed additives. The prime mover of AMR is the misuse and overuse of antimicrobial drugs in human and animal medicine. Antibiotics have been used not only to treat sick animals but also preventively and still in some regions as growth promoters. These practices have created large reservoirs of resistant bacteria in livestock and the environment.
The number of bacteria introduced via feed additives is minuscule compared to the numbers already present in food naturally or in our own gut flora. The human gut already contains about 100 trillion bacteria, many of which carry antimicrobial resistance genes. A probiotic yogurt might contain a few billion lactobacilli. Additionally, consider a raw chicken from a conventional farm: it can be contaminated with millions of bacteria, some resistant due to antibiotics used in the farm. The impact of the resistance of a carefully selected probiotic is negligible compared to the background noise of the entire microbiome and the constant attack of resistant microbes from other sources.
EFSA’s guidance has helped ensure that microorganisms intentionally added to food and feed do not contribute to the spread of AMR. While perhaps being effective in minimizing risk, this approach is conservative and sometimes challenging for innovation. Further refinement towards a balanced, science-based approach would help maintain safety but at the same time supporting innovation in microbial applications.
At Biosafe, we know the ins and outs of testing for AMR, the requirements for genome analysis, authorising GMO products and technical dossier preparation for risk assessments by EFSA.